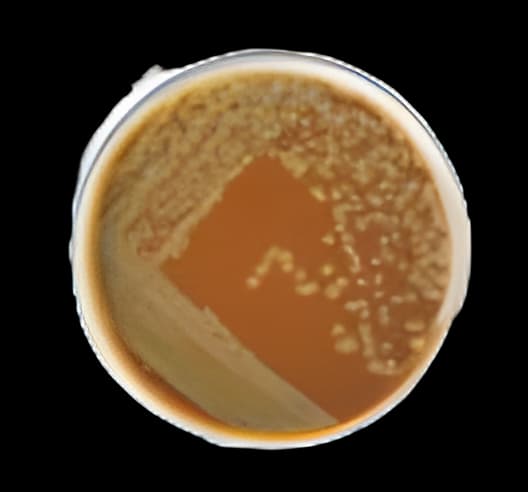
Remel™ Chocolate Agar Brown Mono-Plate - Microbiology Media

Remel™ Chocolate Agar Brown Mono-Plate - 100/Pk for Microbiology Culture Media
USAMP#30997137SKU: R01302Remel™

Product Spotlight
- Brand: Remel™, a trusted name in microbiology culture media
- Manufacturer SKU: R01302, ensuring product authenticity and quality
- Format: Mono-Plate, designed for ease of use in laboratory settings
- Application: Ideal for the cultivation of a wide range of bacteria and fungi, particularly those requiring enriched media
- Quantity: Pack of 100 plates, catering to high-volume laboratory needs
- Storage Requirements: Please refer to the package insert for optimal storage conditions to maintain shelf life
- Rx: Not a prescription product, available for general laboratory use